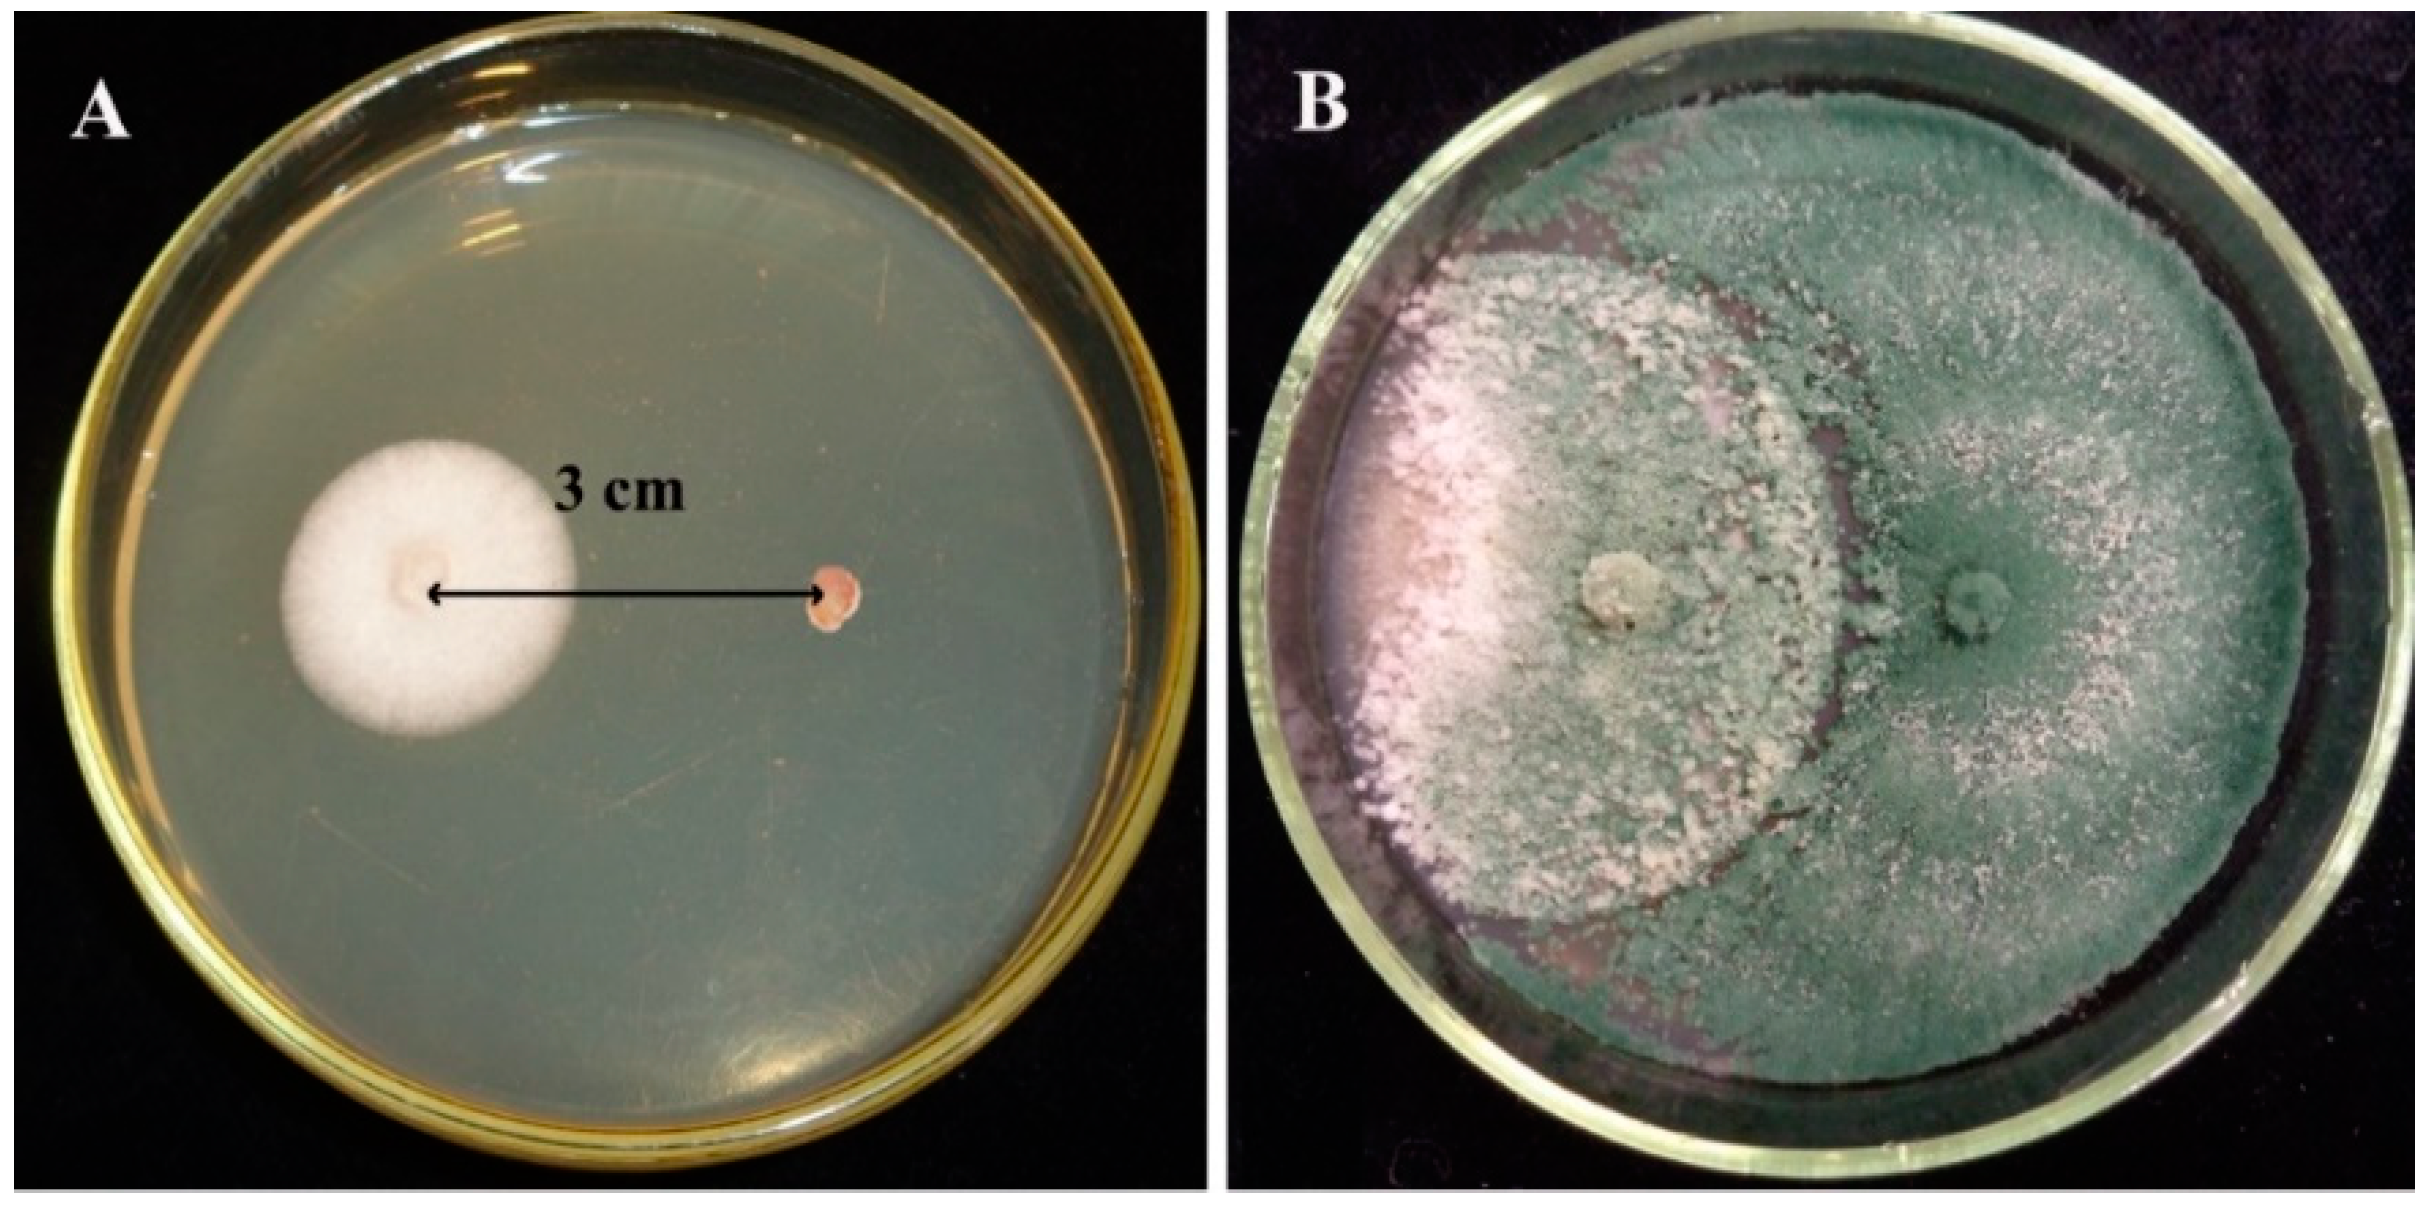
Biomolecules 10 00730 g001 Biomolecules 10 00730 g001
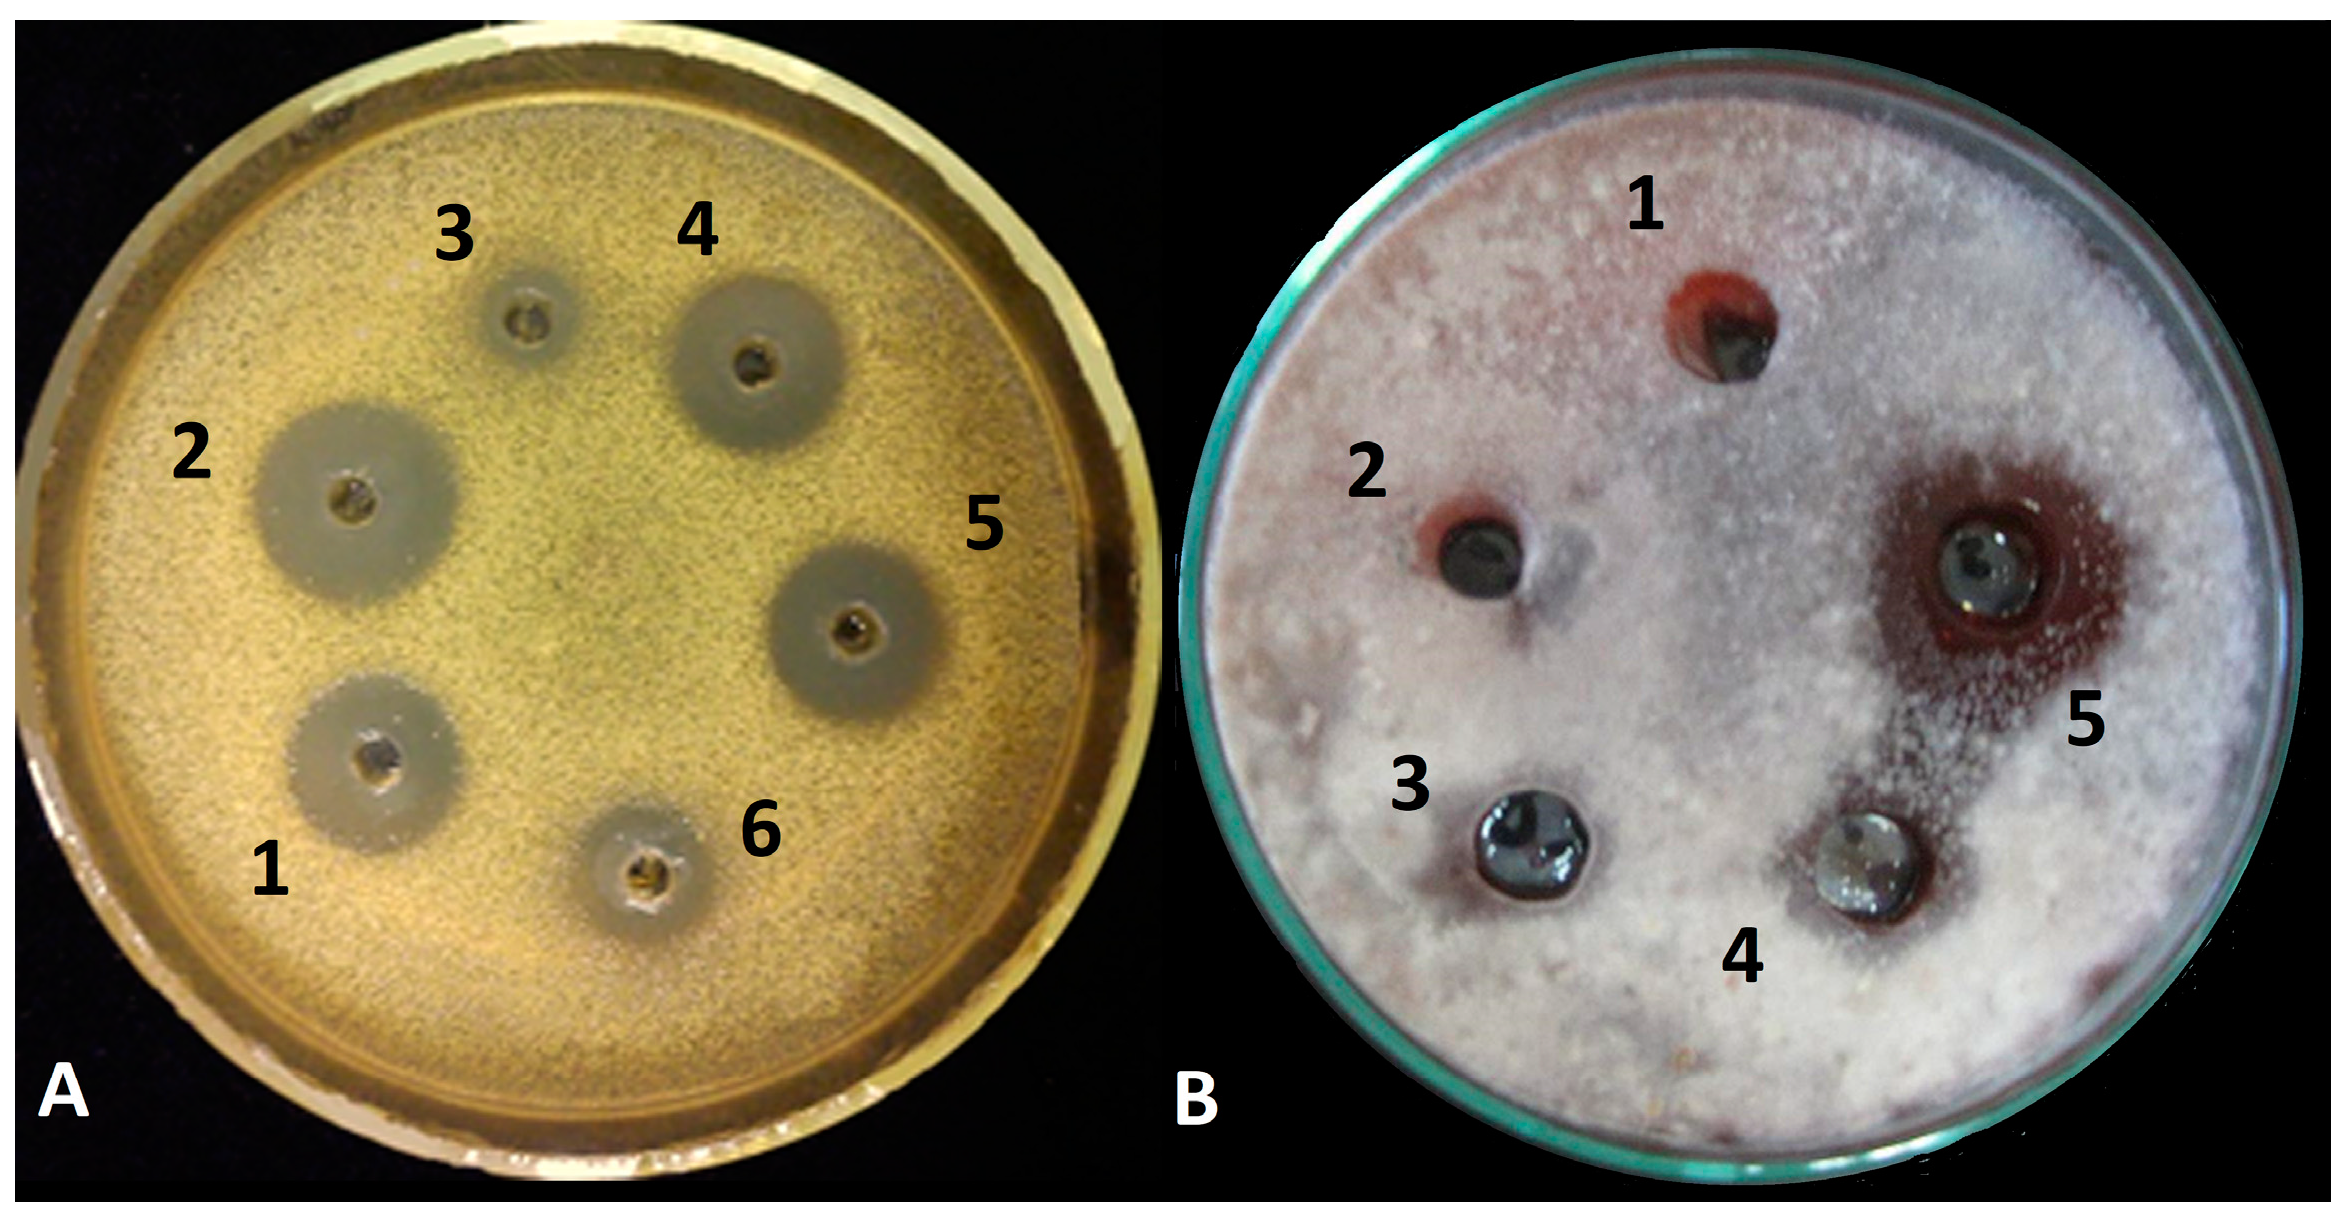
Biomolecules 10 00730 g002 Biomolecules 10 00730 g002
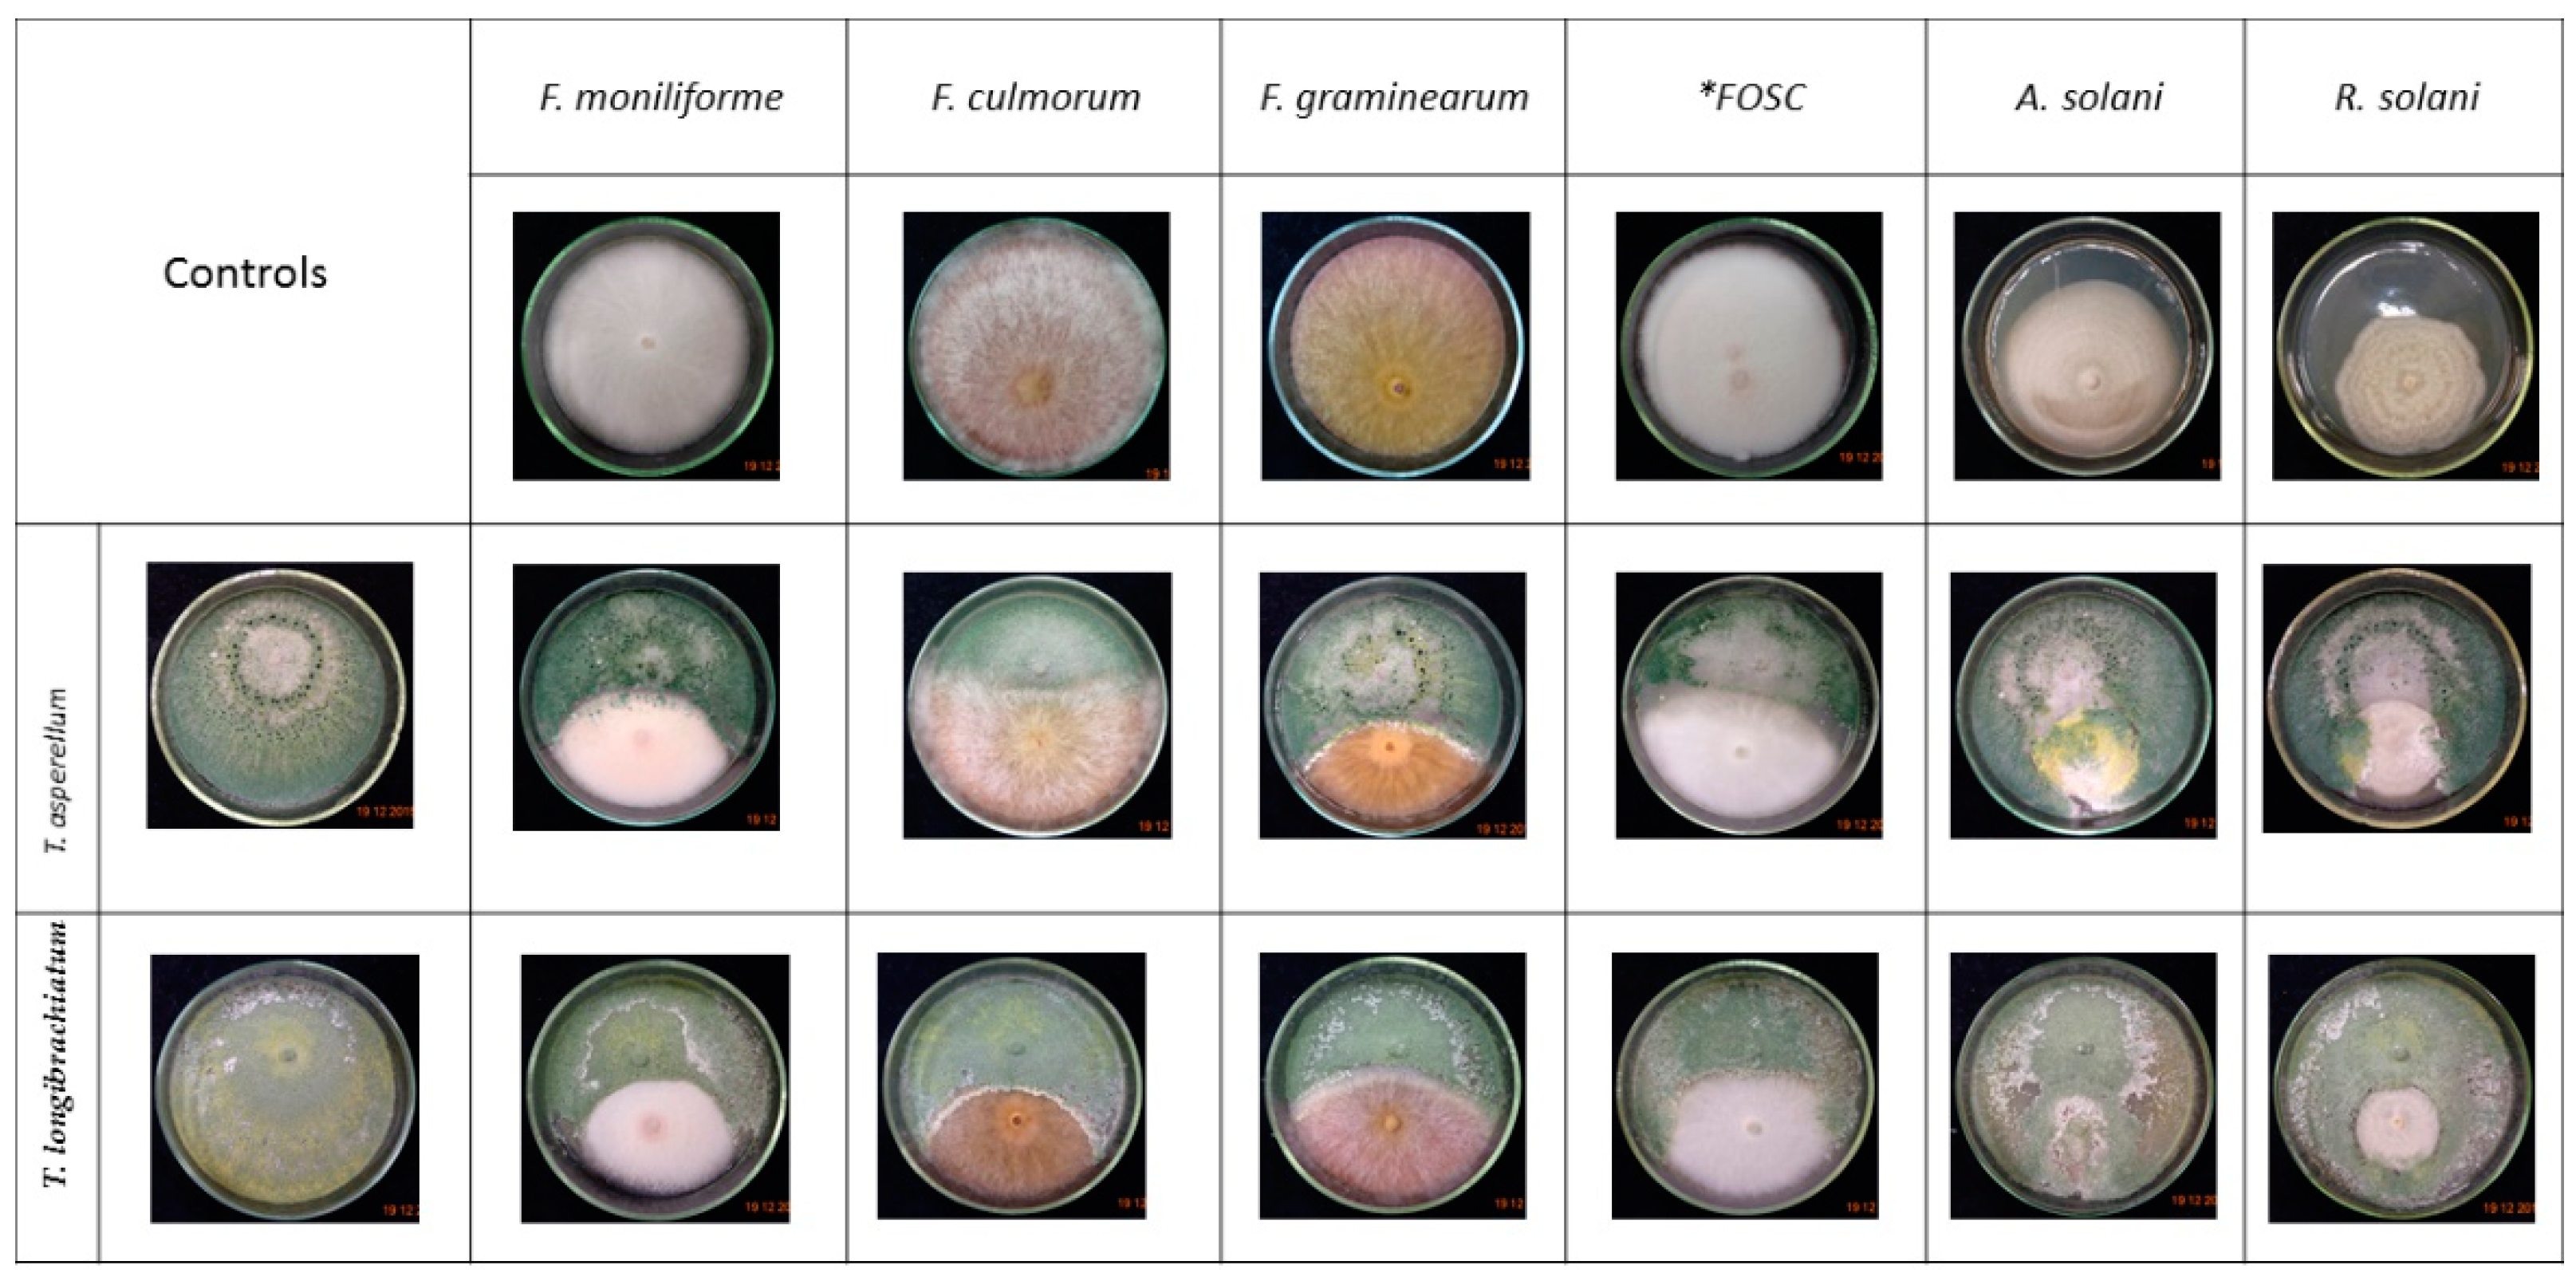
Biomolecules 10 00730 g003 Biomolecules 10 00730 g003

Changes in Peptaibol Production of Trichoderma Species during In Vitro Antagonistic Interactions with Fungal Plant Pathogens
Abstract
1. Introduction
2. Materials and Methods
2.1. Fungal Strains and Culture Conditions
2.2. Direct Confrontation Assays
2.3. Peptaibol Extraction
2.4. Biological Activity of the Crude Extracts
2.5. Identification and Semi-Quantitation of Peptaibols
2.6. RNA Extraction and qRT-PCR for Detection of tex1 Gene Expression
2.7. Statistical Analysis
3. Results
3.1. Inhibitory Activity of Peptaibol Extracts
3.2. Confrontation Experiments
3.3. Changes in Peptaibol Production during Different In Vitro Trichoderma–Plant Pathogen Interactions
3.4. Expression of the tex1 Gene during T. asperellum–R. solani Interaction
4. Discussion
5. Conclusions
Author Contributions
Funding
Acknowledgments
Conflicts of Interest
References
- Dawson, C.J.; Hilton, J. Fertiliser availability in a resource-limited world: Production and recycling of nitrogen and phosphorus. Food Policy 2011, 36, S14–S22. [Google Scholar] [CrossRef]
- Hermosa, R.; Viterbo, A.; Chet, I.; Monte, E. Plant-beneficial effects of Trichoderma and of its genes. Microbiology 2012, 158, 17–25. [Google Scholar] [CrossRef]
- Nawrocka, J.; Małolepsza, U. Diversity in plant systemic resistance induced by Trichoderma. Biol. Control 2013, 67, 149–156. [Google Scholar] [CrossRef]
- Bissett, J.; Gams, W.; Jaklitsch, W.; Samuels, G.J. Accepted Trichoderma names in the year 2015. IMA Fungus 2015, 6, 263–295. [Google Scholar] [CrossRef]
- Zhang, Y.B.; Zhuang, W.Y. New species of Trichoderma in the Harzianum, Longibrachiatum and Viride clades. Phytotaxa 2018, 379, 131–142. [Google Scholar] [CrossRef]
- Zeilinger, S.; Omann, M. Trichoderma biocontrol: Signal transduction pathways involved in host sensing and mycoparasitism. Gene Regul. Syst. Biol. 2007, 1, 227–234. [Google Scholar] [CrossRef] [PubMed]
- Reithner, B.; Ibarra-Laclette, E.; Mach, R.L.; Herrera-Estrella, A. Identification of mycoparasitism-related genes in Trichoderma atroviride. Appl. Environ. Microbiol. 2011, 77, 4361–4370. [Google Scholar] [CrossRef] [PubMed]
- Harman, G.E.; Howell, C.R.; Viterbo, A.; Chet, I.; Lorito, M. Trichoderma species—Opportunistic, avirulent plant symbionts. Nat. Rev. Microbiol. 2004, 2, 43–56. [Google Scholar] [CrossRef] [PubMed]
- Daniel, J.F.S.; Filho, E.S. Peptaibols of Trichoderma. Nat. Prod. Rep. 2007, 24, 1128–1141. [Google Scholar] [CrossRef] [PubMed]
- Kullnig, C.; Mach, R.L.; Lorito, M.; Kubicek, C.P. Enzyme diffusion from Trichoderma atroviride (=T. harzianum P1) to Rhizoctonia solani is a prerequisite for triggering of Trichoderma ech42 gene expression before mycoparasitic contact. Appl. Environ. Microbiol. 2000, 66, 2232–2234. [Google Scholar] [CrossRef]
- Szekeres, A.; Leitgeb, B.; Kredics, L.; Antal, Z.; Hatvani, L.; Manczinger, L.; Vágvölgyi, C. Peptaibols and related peptaibiotics of Trichoderma. Acta Microbiol. Immunol. Hung. 2005, 52, 137–168. [Google Scholar] [CrossRef] [PubMed]
- Zeilinger, S.; Gruber, S.; Bansal, R.; Mukherjee, P. Secondary metabolism in Trichoderma—Chemistry meets genomics. Fungal Biol. Rev. 2016, 30, 74–90. [Google Scholar] [CrossRef]
- Bushley, K.E.; Turgeon, B.G. Phylogenomics reveals subfamilies of fungal nonribosomal peptide synthetases and their evolutionary relationships. BMC Evol. Biol. 2010, 10, 26. [Google Scholar] [CrossRef] [PubMed]
- Marahiel, M.A.; Stachelhaus, T.; Mootz, H.D. Modular peptide synthetases involved in nonribosomal peptide synthesis. Chem. Rev. 1997, 97, 2651–2674. [Google Scholar] [CrossRef] [PubMed]
- Wiest, A.; Grzegorski, D.; Xu, B.-W.; Goulard, C.; Rebuffat, S.; Ebbole, D.J.; Bodo, B.; Kenerley, C. Identification of peptaibols from Trichoderma virens and cloning of a peptaibol synthetase. J. Biol. Chem. 2002, 277, 20862–20868. [Google Scholar] [CrossRef] [PubMed]
- Degenkolb, T.; Berg, A.; Gams, W.; Schlegel, B.; Gräfe, U. The occurrence of peptaibols and structurally related peptaibiotics in fungi and their mass spectrometric identification via diagnostic fragment ions. J. Pept. Sci. 2003, 9, 666–678. [Google Scholar] [CrossRef]
- El-Hajji, M.E.; Rebuffat, S.; Doan, T.L.; Klein, G.; Satre, M.; Bodo, B. Interaction of trichorzianines A and B with model membranes and with the amoeba Dictyostelium. Biochim. Biophys. Acta 1989, 978, 97–104. [Google Scholar] [CrossRef]
- Rebuffat, S.; Goulard, C.; Bodo, B. Antibiotic peptides from Trichoderma harzianum: Harzianins HC, proline-rich 14-residue peptaibols. J. Chem. Soc. Perkin Trans. 1995, 1, 1849–1855. [Google Scholar] [CrossRef]
- Shi, M.; Chen, L.; Wang, X.W.; Zhang, T.; Zhao, P.B.; Song, X.Y.; Sun, C.Y.; Chen, X.L.; Zhou, B.C.; Zhang, Y.Z. Antimicrobial peptaibols from Trichoderma pseudokoningii induce programmed cell death in plant fungal pathogens. Microbiology 2012, 158, 166–175. [Google Scholar] [CrossRef]
- Rebuffat, S.; Prigent, Y.; Auvin-Guette, C.; Bodo, B. Tricholongins BI and BII, 19-residue peptaibols from Trichoderma longibrachiatum. Solution structure from two-dimensional NMR spectroscopy. Eur. J. Biochem. 1991, 201, 661–674. [Google Scholar] [CrossRef]
- Leclerc, G.; Goulard, C.; Prigent, Y.; Bodo, B.; Wróblewski, H.; Rebuffat, S. Sequences and antimycoplasmic properties of longibrachins LGB II and LGB III, two novel 20-residue peptaibols from Trichoderma longibrachiatum. J. Nat. Prod. 2001, 64, 164–170. [Google Scholar] [CrossRef] [PubMed]
- Chutrakul, C.; Alcocer, M.; Bailey, K.; Peberdy, J.F. The production and characterization of trichotoxin peptaibols of Trichoderma asperellum. Chem. Biodivers. 2008, 5, 1694–1706. [Google Scholar] [CrossRef] [PubMed]
- Brückner, H.; Przybylski, M. Isolation and structural characterization of polypeptide antibiotics of the peptaibol class by high-performance liquid chromatography with field desorption and fast atom bombardment mass spectrometry. J. Chromatogr. A 1984, 296, 263–275. [Google Scholar] [CrossRef]
- Jaworski, A.; Brückner, H. Detection of new sequences of peptaibol antibiotics trichotoxins A-40 by on-line liquid chromatography–electrospray ionization mass spectrometry. J. Chromatogr. A 1999, 862, 179–189. [Google Scholar] [CrossRef]
- Suwan, S.; Isobe, M.; Kanokmedhakul, S.; Lourit, N.; Kanokmedhakul, K.; Soytong, K.; Koga, K. Elucidation of high micro-heterogeneity of an acidic–neutral trichotoxin mixture from Trichoderma harzianum by electrospray ionization quadrupole time-of-flight mass spectrometry. J. Mass Spectrom. 2000, 35, 1438–1451. [Google Scholar] [CrossRef]
- Leclerc, G.; Rebuffat, S.; Goulard, C.; Bodo, B. Directed biosynthesis of peptaibol antibiotics in two Trichoderma strains. J. Antibiot. 1998, 51, 170–177. [Google Scholar] [CrossRef]
- Mueller, P.; Rudin, D.O. Action potentials induced in biomolecular lipid membranes. Nature 1968, 217, 713–719. [Google Scholar] [CrossRef]
- Castro, T.G.; Micaêlo, N.M. Modelling of peptaibol analogues incorporating nonpolar α,α-dialkyl glycines shows improved α-helical preorganization and spontaneous membrane permeation. J. Phys. Chem. B 2014, 118, 649–658. [Google Scholar] [CrossRef]
- Chugh, J.K.; Wallace, B.A. Peptaibols: Models for ion channels. Biochem. Soc. Trans. 2001, 29, 565–570. [Google Scholar] [CrossRef]
- Engelberth, J.; Koch, T.; Kuhnemann, F.; Boland, W. Channel-forming peptaibols are potent elicitors of plant secondary metabolism and tendril coiling. Angew. Chem. Int. Ed. Engl. 2000, 39, 1860–1862. [Google Scholar] [CrossRef]
- Luo, Y.; Zhang, D.D.; Dong, X.W.; Zhao, P.B.; Chen, L.L.; Song, X.Y.; Wang, X.J.; Chen, X.L.; Shi, M.; Zhang, Y.Z. Antimicrobial peptaibols induce defense responses and systemic resistance in tobacco against tobacco mosaic virus. FEMS Microbiol. Lett. 2010, 313, 120–126. [Google Scholar] [CrossRef] [PubMed][Green Version]
- Viterbo, A.; Wiest, A.; Brotman, Y.; Chet, I.; Kenerley, C. The 18 mer peptaibols from Trichoderma virens elicit plant defence responses. Mol. Plant Pathol. 2007, 8, 737–746. [Google Scholar] [CrossRef] [PubMed]
- Schirmböck, M.; Lorito, M.; Wang, Y.L.; Hayes, C.K.; Arisan-Atac, I.; Scala, F.; Harman, G.E.; Kubicek, C.P. Parallel formation and synergism of hydrolytic enzymes and peptaibol antibiotics, molecular mechanisms involved in the antagonistic action of Trichoderma harzianum against phytopathogenic fungi. Appl. Environ. Microbiol. 1994, 60, 4364–4370. [Google Scholar] [CrossRef]
- Lorito, M.; Farkas, V.; Rebuffat, S.; Bodo, B.; Kubicek, C.P. Cell wall synthesis is a major target of mycoparasitic antagonism by Trichoderma harzianum. J. Bacteriol. 1996, 178, 6382–6385. [Google Scholar] [CrossRef] [PubMed]
- Vinale, F.; Sivasithamparam, K.; Ghisalberti, E.L.; Woo, S.L.; Nigro, M.; Marra, R.; Lombardi, N.; Pascale, A.; Ruocco, M.; Lanzuise, S.; et al. Trichoderma secondary metabolites active on plants and fungal pathogens. Open Mycol. J. 2014, 8, 127–139. [Google Scholar] [CrossRef]
- Druzhinina, I.S.; Komoń-Zelazowska, M.; Kredics, L.; Hatvani, L.; Antal, Z.; Belayneh, T.; Kubicek, C.P. Alternative reproductive strategies of Hypocrea orientalis and genetically close but clonal Trichoderma longibrachiatum, both capable of causing invasive mycoses of humans. Microbiology 2008, 154, 3447–3459. [Google Scholar] [CrossRef]
- Samuels, G.J.; Ismaiel, A.; Bon, M.C.; De Respinis, S.; Petrini, O. Trichoderma asperellum sensu lato consists of two cryptic species. Mycologia 2010, 102, 944–966. [Google Scholar] [CrossRef]
- Solanki, M.K.; Singh, N.; Singh, R.K.; Singh, P.; Srivastava, A.K.; Kumar, S.; Kashyap, P.L.; Arora, D.K. Plant defense activation and management of tomato root rot by a chitin-fortified Trichoderma/Hypocrea formulation. Phytoparasitica 2011, 39, 471–481. [Google Scholar] [CrossRef]
- Szekeres, A.; Leitgeb, B.; Kredics, L.; Manczinger, L.; Vágvölgyi, C. A novel, image analysis-based method for the evaluation of in vitro antagonism. J. Microbiol. Meth. 2006, 65, 619–622. [Google Scholar] [CrossRef]
- Marik, T.; Várszegi, C.; Kredics, L.; Vágvölgyi, C.; Szekeres, A. Mass spectrometric investigation of alamethicin. Acta Biol. Szeged. 2013, 57, 109–112. [Google Scholar]
- Marik, T.; Szekeres, A.; Várszegi, C.; Czifra, D.; Vágvölgyi, C.; Kredics, L. Rapid bioactivity based pre-screening method for the detection of peptaibiotic-producing Trichoderma strains. Acta Biol. Szeged. 2013, 57, 1–7. [Google Scholar]
- Marik, T.; Tyagi, C.; Racic, G.; Rakk, D.; Szekeres, A.; Vágvölgyi, C.; Kredics, L. New 19-residue peptaibols from Trichoderma clade Viride. Microorganisms 2018, 6, 85. [Google Scholar] [CrossRef] [PubMed]
- Orek, C.O. An optimised cetyltrimethylammonium bromide (CTAB)-based protocol for extracting RNA from young and old cassava leaves. J. Adv. Biol. Biotechnol. 2018, 19, 1–7. [Google Scholar] [CrossRef]
- Pfaffl, M.W. A new mathematical model for relative quantification in real-time RT–PCR. Nucleic Acids Res. 2001, 29, e45. [Google Scholar] [CrossRef] [PubMed]
- Ruijter, J.M.; Ramakers, C.; Hoogaars, W.M.; Karlen, Y.; Bakker, O.; van den Hoff, M.J.; Moorman, A.F. Amplification efficiency: Linking baseline and bias in the analysis of quantitative PCR data. Nucleic Acids Res. 2009, 37, e45. [Google Scholar] [CrossRef]
- Rahimi Tamandegani, P.; Zafari, D.; Marik, T.; Szekeres, A.; Vágvölgyi, C.; Kredics, L. Peptaibol profiles of Iranian Trichoderma isolates. Acta Biol. Hung. 2016, 67, 431–441. [Google Scholar] [CrossRef][Green Version]
- Hatvani, L.; Homa, M.; Chenthamara, K.; Cai, F.; Kocsubé, S.; Atanasova, L.; Mlinaric-Missoni, E.; Manikandan, P.; Revathi, R.; Dóczi, I.; et al. Agricultural systems as potential sources of emerging human mycoses caused by Trichoderma: A successful, common phylotype of Trichoderma longibrachiatum in the frontline. FEMS Microbiol. Lett. 2019, 366, fnz246. [Google Scholar] [CrossRef]
- Mikkola, R.; Andersson, M.A.; Kredics, L.; Grigoriev, P.A.; Sundell, N.; Salkinoja-Salonen, M.S. 20-Residue and 11-residue peptaibols from the fungus Trichoderma longibrachiatum are synergistic in forming Na+/K+-permeable channels and adverse action towards mammalian cells. FEBS J. 2012, 279, 4172–4190. [Google Scholar] [CrossRef]
- Marik, T.; Tyagi, C.; Balázs, D.; Urbán, P.; Szepesi, Á.; Bakacsy, L.; Endre, G.; Rakk, D.; Szekeres, A.; Andersson, M.A.; et al. Structural diversity and bioactivities of peptaibol compounds from the Longibrachiatum clade of the filamentous fungal genus Trichoderma. Front. Microbiol. 2019, 10, 1434. [Google Scholar] [CrossRef]
- Naeimi, S.; Okhovvat, S.M.; Javan-Nikkhah, M.; Vágvölgyi, C.; Khosravi, V.; Kredics, L. Biological control of Rhizoctonia solani AG1-1A, the causal agent of rice sheath blight with Trichoderma strains. Phytopathol. Med. 2010, 49, 287–300. [Google Scholar] [CrossRef]
- Kubicek, C.P.; Herrera-Estrella, A.; Seidl-Seiboth, V.; Martinez, D.A.; Druzhinina, I.S.; Thon, M.; Zeilinger, S.; Casas-Flores, S.; Horwitz, B.A.; Mukherjee, P.K.; et al. Comparative genome sequence analysis underscores mycoparasitism as the ancestral life style of Trichoderma. Genome Biol. 2011, 12, R40. [Google Scholar] [CrossRef] [PubMed]
- Mukherjee, P.K.; Horwitz, B.A.; Herrera-Estrella, A.; Schmoll, M.; Kenerley, C.M. Trichoderma research in the genome era. Annu. Rev. Phytopathol. 2013, 51, 105–129. [Google Scholar] [CrossRef] [PubMed]
- Neumann, N.K.N.; Stoppacher, N.; Zeilinger, S.; Degenkolb, T.; Brückner, H.; Schuhmacher, R. The peptaibiotics database—A comprehensive online resource. Chem. Biodivers. 2015, 12, 743–751. [Google Scholar] [CrossRef] [PubMed]
- Degenkolb, T.; Fog Nielsen, K.; Dieckmann, R.; Branco-Rocha, F.; Chaverri, P.; Samuels, G.J.; Thrane, U.; von, D.H.; Vilcinskas, A.; Brückner, H. Peptaibol, secondary-metabolite, and hydrophobin pattern of commercial biocontrol agents formulated with species of the Trichoderma harzianum complex. Chem. Biodivers. 2015, 12, 662–684. [Google Scholar] [CrossRef]
- Pakdaman, B.S.; Mohammadi Goltapeh, E.; Mohammad Soltani, B.; Talebi, A.A.; Nadepoor, M.; Kruszewska, J.S.; Piłsyk, S.; Sarrocco, S.; Vannacci, G. Toward the quantification of confrontation (dual culture) test: A case study on the biological control of Pythium aphanidermatum with Trichoderma asperelloides. J. Biofertil. Biopestic. 2013, 4, 1000137. [Google Scholar] [CrossRef]
- Degenkolb, T.; Dieckmann, R.; Nielsen, K.F.; Gräfenhan, T.; Theis, C.; Zafari, D.; Chaverri, P.; Ismaiel, A.; Brückner, H.; von Döhren, H.; et al. The Trichoderma brevicompactum clade: A separate lineage with new species, new peptaibiotics, and mycotoxins. Mycol. Progress 2008, 7, 177–219. [Google Scholar] [CrossRef]
- Meyer, C.E.; Reusser, F. A polypeptide antibacterial agent isolated from Trichoderma viride. Experientia 1967, 23, 85–86. [Google Scholar] [CrossRef]
- Fuji, K.; Fujita, E.; Takaishi, Y.; Fujita, T.; Arita, I.; Komatsu, M.; Hiratsuka, N. New antibiotics, trichopolyns A and B: Isolation and biological activity. Experientia 1978, 34, 237–239. [Google Scholar] [CrossRef]
- Marik, T.; Urbán, P.; Tyagi, C.; Szekeres, A.; Leitgeb, B.; Vágvölgyi, M.; Manczinger, L.; Druzhinina, I.S.; Vágvölgyi, C.; Kredics, L. Diversity profile and dynamics of peptaibols produced by green mould Trichoderma species in interactions with their hosts Agaricus bisporus and Pleurotus ostreatus. Chem. Biodivers. 2017, 14, e1700033. [Google Scholar] [CrossRef]
- d’Enfert, C. Fungal spore germination: Insights from the molecular genetics of Aspergillus nidulans and Neurospora crassa. Fungal Genet. Biol. 1997, 21, 163–172. [Google Scholar] [CrossRef]
- Katayama, T.; Miyagawa, K.; Kodama, T.; Oikawa, S. Trichorzin HA V, a member of the peptaibol family, stimulates intracellular cAMP formation in cells expressing the calcitonin receptor. Biol. Pharm. Bull. 2001, 24, 1420–1422. [Google Scholar] [CrossRef] [PubMed][Green Version]
- Hatanaka, M.; Shimoda, C. The cyclic AMP/PKA signal pathway is required for initiation of spore germination in Schizosaccharomyces pombe. Yeast 2000, 18, 207–217. [Google Scholar] [CrossRef]
- Mukherjee, M.; Mukherjee, P.K.; Kale, S.P. cAMP signaling is involved in growth, germination, mycoparasitism and secondary metabolism in Trichoderma virens. Microbiology 2007, 153, 1734–1742. [Google Scholar] [CrossRef] [PubMed]
- Przybylski, M.; Dietrich, I.; Manz, I.; Brückner, H. Elucidation of structure microheterogeneity of the polypeptide antibiotics paracelsin and trichotoxin A-50 by fast atom bombardment mass spectrometry in combination with selective in situ hydrolysis. Biomed. Mass Spectrom. 1984, 11, 569–582. [Google Scholar] [CrossRef]
- Tyagi, C.; Marik, T.; Szekeres, A.; Vágvölgyi, C.; Kredics, L.; Ötvös, F. Tripleurin XIIc: Peptide folding dynamics in aqueous and hydrophobic environment mimic using accelerated molecular dynamics. Molecules 2019, 24, 358. [Google Scholar] [CrossRef] [PubMed]
- Whitmore, L.; Wallace, B.A. Analysis of peptaibol sequence composition: Implications for in vivo synthesis and channel formation. Eur. Biophys. J. 2004, 33, 233–237. [Google Scholar] [CrossRef]
- Agarwalla, S.; Mellor, I.R.; Sansom, M.S.; Karle, I.L.; Flippen-Anderson, J.L.; Uma, K.; Krishna, K.; Sukumar, M.; Balaram, P. Zervamicins, a structurally characterised peptide model for membrane ion channels. Biochem. Biophys. Res. Commun. 1992, 186, 8–15. [Google Scholar] [CrossRef]
- Cosette, P.; Rebuffat, S.; Bodo, B.; Molle, G. The ion-channel activity of longibrachins LGA I and LGB II: Effects of Pro-2/Ala and Gln-18/Glu substitutions on the alamethicin voltage-gated membrane channels. Biochim. Biophys. Acta 1999, 1461, 113–122. [Google Scholar] [CrossRef][Green Version]
- Tata, A.; Perez, C.; Campos, M.L.; Bayfield, M.A.; Eberlin, M.N.; Ifa, D.R. Imprint desorption electrospray ionization mass spectrometry imaging for monitoring secondary metabolites production during antagonistic interaction of fungi. Anal. Chem. 2015, 87, 12298–12305. [Google Scholar] [CrossRef]
- Vinale, F.; Ghisalberti, E.L.; Sivasithamparam, K.; Marra, R.; Ritieni, A.; Ferracane, R.; Woo, S.; Lorito, M. Factors affecting the production of Trichoderma harzianum secondary metabolites during the interaction with different plant pathogens. Lett. Appl. Microbiol. 2009, 48, 705–711. [Google Scholar]
- Holzlechner, M.; Reitschmidt, S.; Gruber, S.; Zeilinger, S.; Marchetti-Deschmann, M. Visualizing fungal metabolites during mycoparasitic interaction by MALDI mass spectrometry imaging. Proteomics 2016, 16, 1742–1746. [Google Scholar] [CrossRef] [PubMed]
- Quandt, C.A.; Bushley, K.E.; Spatafora, J.W. The genome of the truffle-parasite Tolypocladium ophioglossoides and the evolution of antifungal peptaibiotics. BMC Genomics 2015, 16, 553. [Google Scholar] [CrossRef] [PubMed]

| T. asperellum IRAN 3062C | Peak | M | b12 | y6 | R | R1 | R2 | R3 | R4 | R5 | R6 | R7 | R8 | R9 | R10 | R11 | R12 | R13 | R14 | R15 | R16 | R17 | R18 | ||
| Pept-1705-a-1 | 1 | 1705 | 1094 | 612 | Ac | Aib | Gly | Aib | Lxx | Aib | Gln | Aib | Aib | Ala | Ser | Aib | Aib | Pro | Lxx | Aib | Aib | Gln | Vxxol | ||
| Pept-1689-a-1 | 2 | 1689 | 1079 | 612 | Ac | Aib | Gly | Aib | Lxx | Aib | Gln | Aib | Aib | Ala | Aib | Ala | Aib | Pro | Lxx | Aib | Aib | Gln | Vxxol | ||
| Pept-1689-a-2 | 2 | 1689 | 1079 | 612 | Ac | Aib | Gly | Aib | Lxx | Aib | Gln | Aib | Aib | Ala | Aib | Ala | Aib | Pro | Lxx | Aib | Aib | Gln | Vxxol | ||
| Pept-1691-a-1 | 2 | 1691 | 1081 | 612 | Ac | Aib | Gly | Aib | Lxx | Aib | Gln | Aib | Aib | Ala | Ser | Ala | Aib | Pro | Lxx | Aib | Aib | Gln | Vxxol | ||
| Pept-1705-a-2 | 2 | 1705 | 1094 | 612 | Ac | Aib | Gly | Aib | Lxx | Aib | Gln | Aib | Aib | Aib | Ser | Ala | Aib | Pro | Lxx | Aib | Aib | Gln | Vxxol | ||
| Pept-1719-b-1 | 3 | 1719 | 1094 | 626 | Ac | Aib | Gly | Aib | Lxx | Aib | Gln | Aib | Aib | Aib | Ser | Ala | Aib | Pro | Lxx | Aib | Vxx | Gln | Vxxol | ||
| Pept-1719-a-1 | 3 | 1719 | 1108 | 612 | Ac | Aib | Gly | Aib | Lxx | Aib | Gln | Aib | Aib | Aib | Ser | Aib | Aib | Pro | Lxx | Aib | Aib | Gln | Vxxol | ||
| Pept-1705-a-3 | 3 | 1705 | 1094 | 612 | Ac | Aib | Gly | Aib | Lxx | Aib | Gln | Aib | Aib | Aib | Ser | Ala | Aib | Pro | Lxx | Aib | Aib | Gln | Vxxol | ||
| Pept-1703-a-1 | 3 | 1703 | 1092 | 612 | Ac | Aib | Gly | Aib | Lxx | Aib | Gln | Aib | Aib | Aib | Aib | Ala | Aib | Pro | Lxx | Aib | Aib | Gln | Vxxol | ||
| Pept-1749-b-1 | 3 | 1749 | 1123 | 626 | Ac | Aib | Gly | Aib | Lxx | Aib | Gln | Aib | Aib | Aib | Ser | Vxx | Aib | Pro | Lxx | Aib | Vxx | Gln | Vxxol | ||
| Trichotoxin T5D2/Pept-1675-a-1 | 4 | 1675 | 1064 | 612 | Ac | Aib | Gly | Aib | Lxx | Aib | Gln | Aib | Aib | Ala | Ala | Ala | Aib | Pro | Lxx | Aib | Aib | Gln | Vxxol | ||
| Pept-1719-b-2 | 4 | 1719 | 1094 | 626 | Ac | Aib | Gly | Aib | Lxx | Aib | Gln | Aib | Aib | Aib | Ser | Ala | Aib | Pro | Lxx | Aib | Vxx | Gln | Vxxol | ||
| Pept-1733-b-1 | 4 | 1733 | 1108 | 626 | Ac | Aib | Gly | Aib | Lxx | Aib | Gln | Aib | Aib | Aib | Ser | Aib | Aib | Pro | Lxx | Aib | Vxx | Gln | Vxxol | ||
| Trichotoxin A-50 F (T5F)/Pept-1689-b-1 | 4 | 1689 | 1064 | 626 | Ac | Aib | Gly | Aib | Lxx | Aib | Gln | Aib | Aib | Ala | Ala | Ala | Aib | Pro | Lxx | Aib | Vxx | Gln | Vxxol | ||
| Trichotoxin A-50 E (T5E)/Pept-1689-a-3 | 4 | 1689 | 1079 | 612 | Ac | Aib | Gly | Aib | Lxx | Aib | Gln | Aib | Aib | Aib | Ala | Ala | Aib | Pro | Lxx | Aib | Aib | Gln | Vxxol | ||
| Pept-1733-b-2 | 4 | 1733 | 1108 | 626 | Ac | Aib | Gly | Aib | Lxx | Aib | Gln | Aib | Aib | Aib | Ser | Aib | Aib | Pro | Lxx | Aib | Vxx | Gln | Vxxol | ||
| Trichotoxin A-50 F (T5F)/Pept-1689-b-2 | 5 | 1689 | 1064 | 626 | Ac | Aib | Gly | Aib | Lxx | Aib | Gln | Aib | Aib | Ala | Ala | Ala | Aib | Pro | Lxx | Aib | Vxx | Gln | Vxxol | ||
| Pept-1733-b-3 | 5 | 1733 | 1108 | 626 | Ac | Aib | Gly | Aib | Lxx | Aib | Gln | Aib | Aib | Aib | Ser | Aib | Aib | Pro | Lxx | Aib | Vxx | Gln | Vxxol | ||
| Trichotoxin sequence 05/Pept-1703-a-2 | 5 | 1703 | 1092 | 612 | Ac | Aib | Gly | Aib | Lxx | Aib | Gln | Aib | Aib | Aib | Ala | Aib | Aib | Pro | Lxx | Aib | Aib | Gln | Vxxol | ||
| Pept-1703-b-1 | 5 | 1703 | 1078 | 626 | Ac | Aib | Gly | Aib | Lxx | Aib | Gln | Aib | Ala | Aib | Ala | Aib | Aib | Pro | Lxx | Aib | Vxx | Gln | Vxxol | ||
| Pept-1733-b-4 | 5 | 1733 | 1108 | 626 | Ac | Aib | Gly | Aib | Lxx | Aib | Gln | Aib | Aib | Aib | Ser | Aib | Aib | Pro | Lxx | Aib | Vxx | Gln | Vxxol | ||
| Pept-1703-b-2 | 6 | 1703 | 1078 | 626 | Ac | Aib | Gly | Aib | Gln | Aib | Gln | Aib | Aib | Aib | Gly | Ala | Aib | Pro | Lxx | Aib | Vxx | Gln | Vxxol | ||
| Pept-1747-b-1 | 6 | 1747 | 1122 | 626 | Ac | Aib | Gly | Aib | Gln | Aib | Gln | Aib | Aib | Aib | Aib | Aib | Aib | Pro | Lxx | Aib | Vxx | Gln | Vxxol | ||
| Pept-1703-b-3 | 6 | 1703 | 1078 | 626 | Ac | Aib | Gly | Aib | Lxx | Aib | Gln | Aib | Ala | Aib | Ala | Aib | Aib | Pro | Lxx | Aib | Vxx | Gln | Vxxol | ||
| Pept-1733-b-5 | 6 | 1733 | 1108 | 626 | Ac | Aib | Gly | Aib | Lxx | Aib | Gln | Aib | Aib | Aib | Ser | Aib | Aib | Pro | Lxx | Aib | Vxx | Gln | Vxxol | ||
| Trichotoxin A-50 I (T5I)/Pept-1717-b-1 | 6 | 1717 | 1092 | 626 | Ac | Aib | Gly | Aib | Lxx | Aib | Gln | Aib | Aib | Aib | Ala | Aib | Aib | Pro | Lxx | Aib | Vxx | Gln | Vxxol | ||
| Pept-1731-b-1 | 7 | 1731 | 1106 | 626 | Ac | Aib | Ala | Aib | Lxx | Aib | Gln | Aib | Aib | Aib | Ala | Aib | Aib | Pro | Lxx | Aib | Vxx | Gln | Vxxol | ||
| Trichotoxin A-50J (T5J)/Pept-1731-b-2 | 8 | 1731 | 1106 | 626 | Ac | Aib | Gly | Aib | Lxx | Aib | Gln | Aib | Aib | Aib | Aib | Aib | Aib | Pro | Lxx | Aib | Vxx | Gln | Vxxol | ||
| General structure | - | - | - | Ac | Aib | ◆ | Aib | ● | Aib | Gln | Aib | ■ | ■ | 🟄 | ⬟ | Aib | Pro | Lxx | Aib | ▲ | Gln | Vxxol | |||
| T. longibrachiatum IRAN 3067C | Peak | M | b13 | y7 | R | R1 | R2 | R3 | R4 | R5 | R6 | R7 | R8 | R9 | R10 | R11 | R12 | R13 | R14 | R15 | R16 | R17 | R18 | R19 | R20 |
| Longibrachin A II/Trilongin B II/Pept-1951-d | 1 | 1951 | 1974 | 789 | Ac | Aib | Ala | Aib | Ala | Aib | Ala | Gln | Aib | Vxx | Aib | Gly | Lxx | Aib | Pro | Vxx | Aib | Vxx | Glu | Gln | Pheol |
| Longibrachin A I/Trilongin B I/Pept-1936-a | 1 | 1936 | 1959 | 774 | Ac | Aib | Ala | Aib | Ala | Aib | Ala | Gln | Aib | Vxx | Aib | Gly | Lxx | Aib | Pro | Vxx | Aib | Aib | Gln | Gln | Pheol |
| Longibrachin B II/Trilongin C I/Pept-1938-b | 1 | 1938 | 1961 | 775 | Ac | Aib | Ala | Aib | Ala | Aib | Ala | Gln | Aib | Vxx | Aib | Gly | Lxx | Aib | Pro | Vxx | Aib | Aib | Glu | Gln | Pheol |
| Pept-1951-c | 1 | 1951 | 1974 | 788 | Ac | Aib | Ala | Aib | Ala | Aib | Ala | Gln | Aib | Aib | Vxx | Gly | Lxx | Aib | Pro | Vxx | Aib | Vxx | Gln | Gln | Pheol |
| Pept-1952-d | 1 | 1952 | 1975 | 789 | Ac | Aib | Ala | Aib | Ala | Aib | Ala | Gln | Aib | Aib | Vxx | Gly | Lxx | Aib | Pro | Vxx | Aib | Vxx | Glu | Gln | Pheol |
| Longibrachin A III/Pept-1951-a | 2 | 1951 | 1974 | 774 | Ac | Aib | Ala | Aib | Ala | Aib | Aib | Gln | Aib | Vxx | Aib | Gly | Lxx | Aib | Pro | Vxx | Aib | Aib | Gln | Gln | Pheol |
| Longibrachin B III/Trilongin C III/Pept-1951-b | 2 | 1951 | 1974 | 775 | Ac | Aib | Ala | Aib | Ala | Aib | Aib | Gln | Aib | Vxx | Aib | Gly | Lxx | Aib | Pro | Vxx | Aib | Aib | Glu | Gln | Pheol |
| Pept-1965-c-1 | 3 | 1965 | 1988 | 788 | Ac | Aib | Ala | Aib | Ala | Aib | Aib | Gln | Aib | Ala | Lxx | Gly | Lxx | Aib | Pro | Vxx | Aib | Vxx | Gln | Gln | Pheol |
| Pept-1966-d | 3 | 1966 | 1988 | 789 | Ac | Aib | Ala | Aib | Ala | Aib | Aib | Gln | Aib | Ala | Lxx | Gly | Lxx | Aib | Pro | Vxx | Aib | Vxx | Glu | Gln | Pheol |
| Pept-1965-c-2 | 4 | 1965 | 1988 | 788 | Ac | Aib | Ala | Aib | Ala | Aib | Aib | Gln | Aib | Ala | Lxx | Gly | Lxx | Aib | Pro | Vxx | Aib | Vxx | Gln | Gln | Pheol |
| General structure | - | - | - | Ac | Aib | Ala | Aib | Ala | Aib | ■ | Gln | Aib | ⬟ | 🟎 | Gly | Lxx | Aib | Pro | Vxx | Aib | ▲ | ▼ | Gln | Pheol | |
© 2020 by the authors. Licensee MDPI, Basel, Switzerland. This article is an open access article distributed under the terms and conditions of the Creative Commons Attribution (CC BY) license (http://creativecommons.org/licenses/by/4.0/).
Share and Cite
Rahimi Tamandegani, P.; Marik, T.; Zafari, D.; Balázs, D.; Vágvölgyi, C.; Szekeres, A.; Kredics, L. Changes in Peptaibol Production of Trichoderma Species during In Vitro Antagonistic Interactions with Fungal Plant Pathogens. Biomolecules 2020, 10, 730. https://doi.org/10.3390/biom10050730
Rahimi Tamandegani P, Marik T, Zafari D, Balázs D, Vágvölgyi C, Szekeres A, Kredics L. Changes in Peptaibol Production of Trichoderma Species during In Vitro Antagonistic Interactions with Fungal Plant Pathogens. Biomolecules. 2020; 10(5):730. https://doi.org/10.3390/biom10050730
Chicago/Turabian StyleRahimi Tamandegani, Parisa, Tamás Marik, Doustmorad Zafari, Dóra Balázs, Csaba Vágvölgyi, András Szekeres, and László Kredics. 2020. "Changes in Peptaibol Production of Trichoderma Species during In Vitro Antagonistic Interactions with Fungal Plant Pathogens" Biomolecules 10, no. 5: 730. https://doi.org/10.3390/biom10050730
APA StyleRahimi Tamandegani, P., Marik, T., Zafari, D., Balázs, D., Vágvölgyi, C., Szekeres, A., & Kredics, L. (2020). Changes in Peptaibol Production of Trichoderma Species during In Vitro Antagonistic Interactions with Fungal Plant Pathogens. Biomolecules, 10(5), 730. https://doi.org/10.3390/biom10050730

